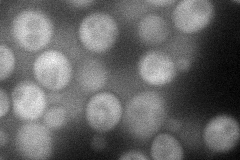
YOR134W
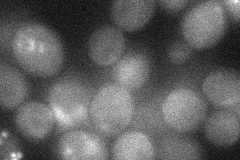
YOR134W

View description
Rho GTPase activating protein (RhoGAP), stimulates the intrinsic GTPase activity of Rho1p, which plays a role in actin cytoskeleton organization and control of cell wall synthesis; structurally and functionally related to Sac7p
Localization:
Intensity:
Fold change:
Significance:
-
C’ GFP library in SD

below threshold18.68 -
N' NOP1pr-GFP in SD
cytosol51.4191 -
N' TEF2pr-mCherry in SD

cytosol35.3552 -
N' NATIVEpr-GFP in SD

below threshold20.366 -
N' TEF2pr-VC and Cyto-VN in SD
cytosol29.028 -
C’ GFP library in SD+DTT

cytosol18.390.98No -
C’ GFP library in SD+H2O2

cytosol15.80.84No -
C’ GFP library in Starvation Media

cytosol20.681.1No -
C’ GFP library on the background of Pup2-DaMP

below threshold -
C’ GFP library on the background of CCT mutant

below threshold19.46991.04169No
